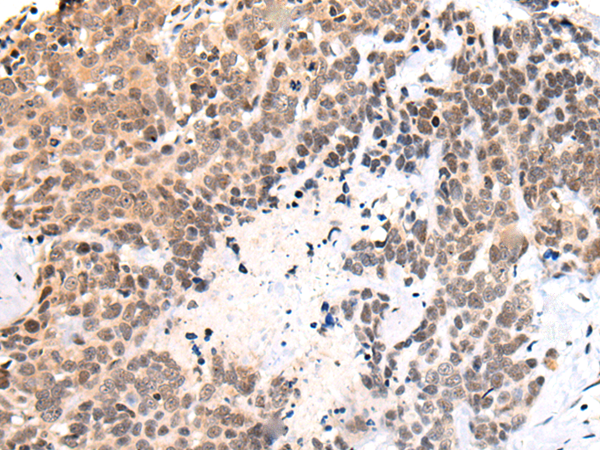

-
分类: 科研抗体货号: P12960别名: BDPL应用: WB,IHC反应种属: Human, Mouse
-
分类: 科研抗体货号: P12934别名: EDSP2; SEMDJL1; beta3GalT6应用: IHC反应种属: Human, Mouse
-
分类: 科研抗体货号: P12959别名:应用: IHC反应种属: Human
-
分类: 科研抗体货号: P12949别名: BIG1; P200; ARFGEP1应用: IHC反应种属: Human, Mouse, Rat
-
分类: 科研抗体货号: P12958别名: CELF-5; BRUNOL5; BRUNOL-5应用: IHC反应种属: Human
-
分类: 科研抗体货号: P12948别名: SMALED2; SMALED2A; SMALED2B; bA526D8.1应用: IHC反应种属: Human
-
分类: 科研抗体货号: P12979别名: ROX; NO66; JMJD9; MAPJD; URLC2; hsNO66; C14orf169应用: IHC反应种属: Human, Mouse, Rat
-
分类: 科研抗体货号: P12957别名: ORFX; RING3L应用: IHC反应种属: Human, Mouse
-
分类: 科研抗体货号: P12977别名: AWMS3; MEDA4; MEDA-4; hAWMS3; C13orf33应用: WB,IHC反应种属: Human, Mouse
-
分类: 科研抗体货号: P12956别名: APA; CD249; gp160应用: IHC反应种属: Human, Mouse, Rat

鄂公网安备42018502007531号
鄂公网安备42018502007531号

